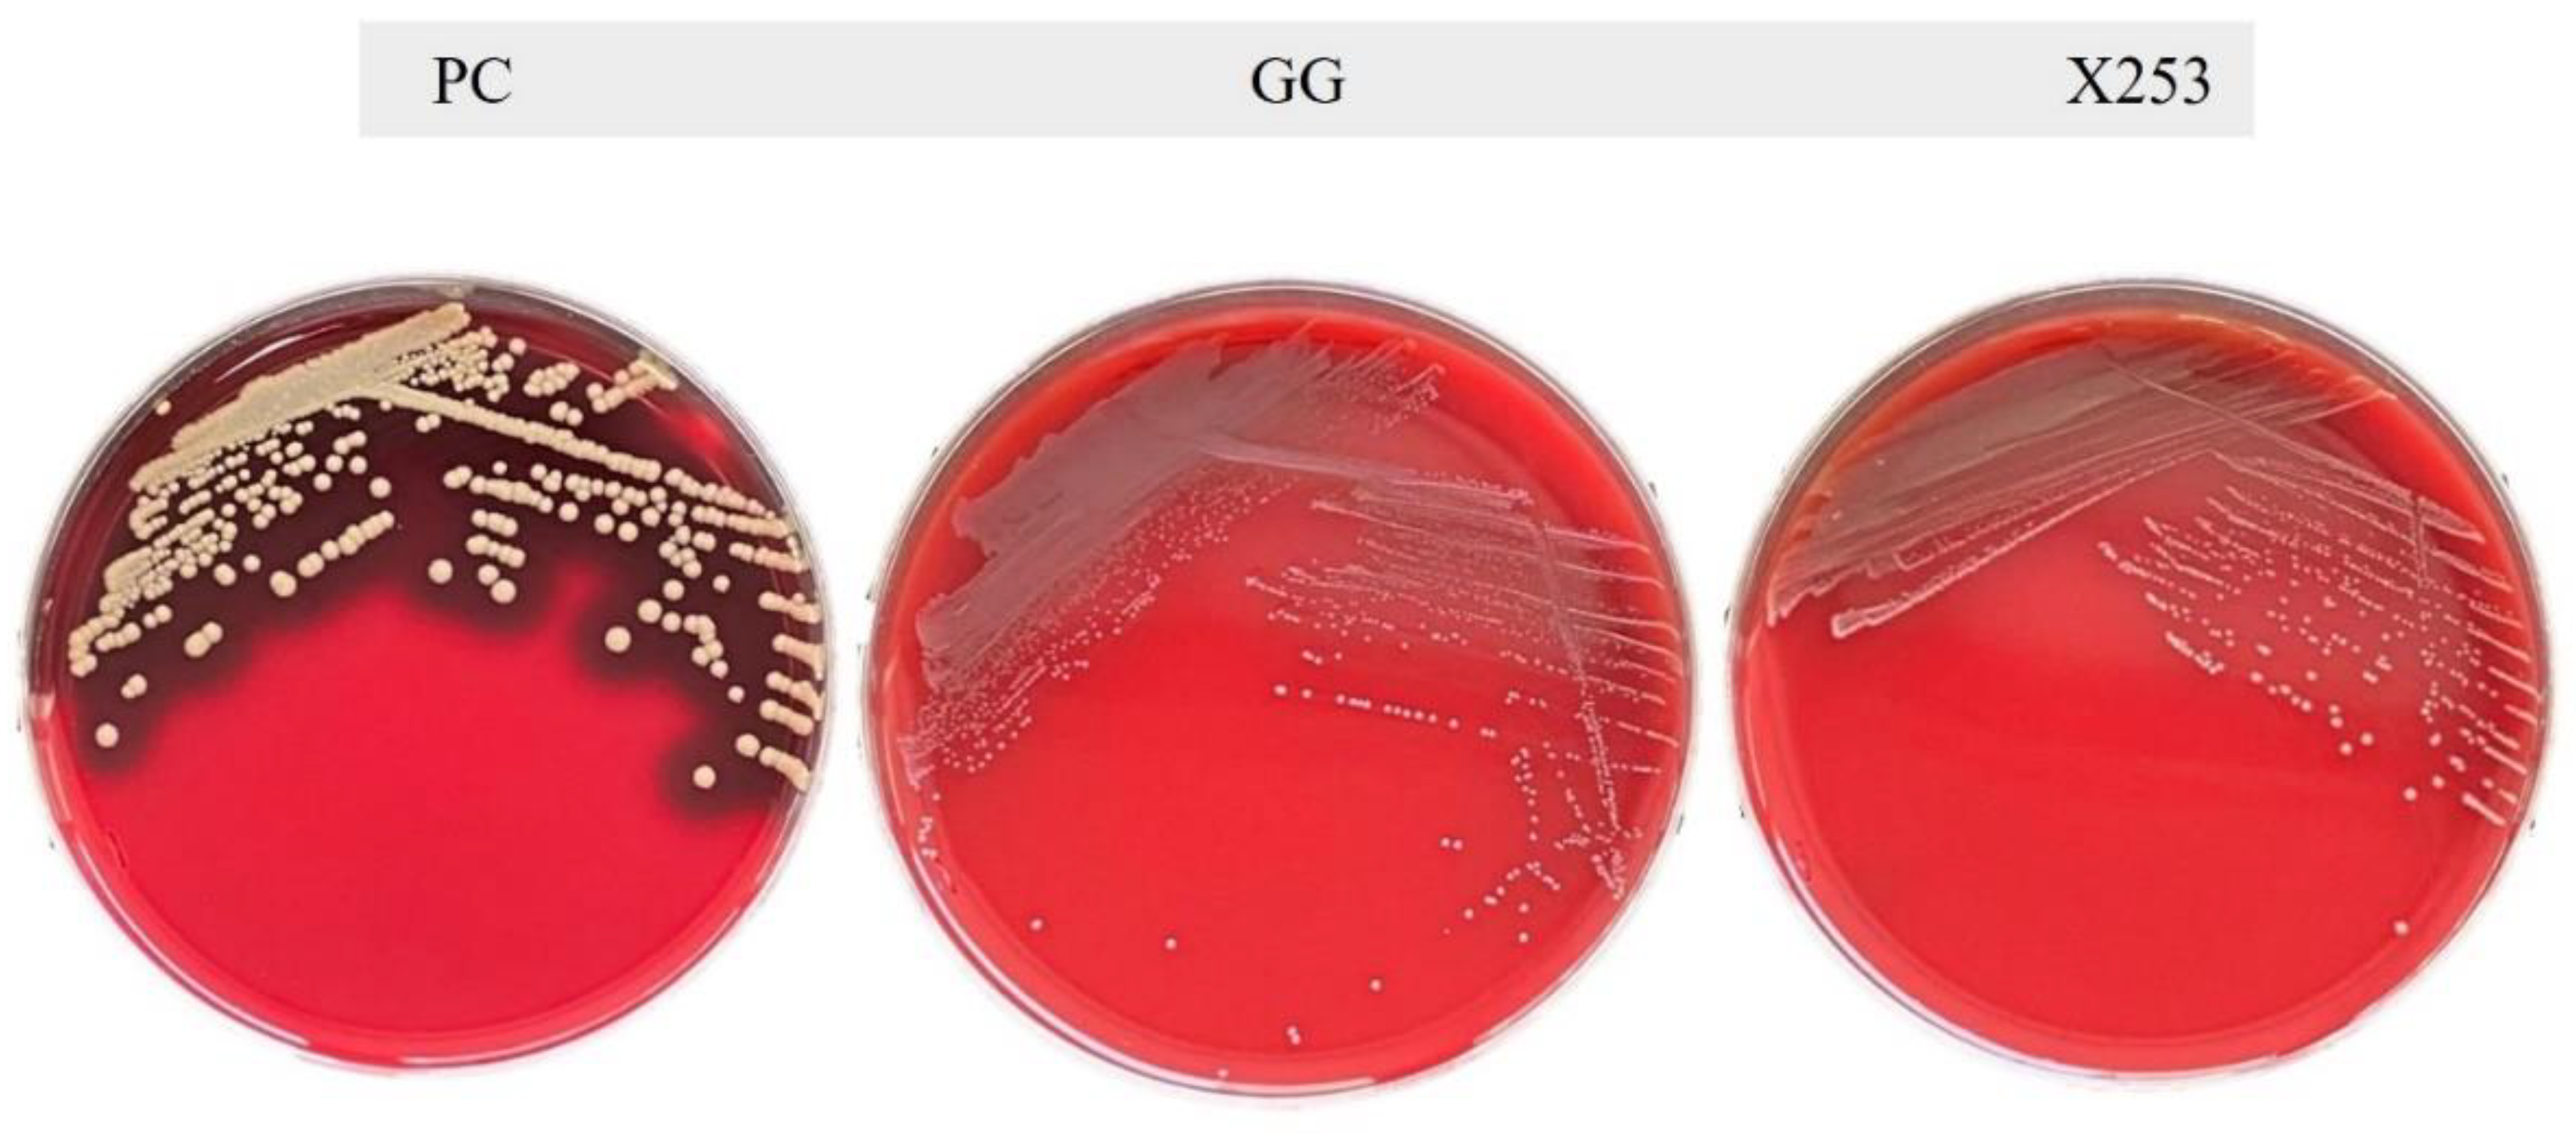
Microorganisms 11 00140 g003 Microorganisms 11 00140 g003

Abstract
Lacticaseibacillus rhamnosus is a generalist that can adapt to different ecological niches, serving as a valuable source of probiotics. The genome of L. rhamnosus X253 contains one chromosome and no plasmids, with a size of 2.99 Mb. Both single-copy orthologous gene-based phylogenetic analysis and average nucleotide identity indicated that dairy-derived L. rhamnosus X253 was most closely related to the human-intestine-derived strain L. rhamnosus LOCK908, rather than other dairy strains. The adaptation of L. rhamnosus X253 and the human-intestine-derived strain L. rhamnosus GG to different ecological niches was explained by structural variation analysis and COG annotation. Hemolytic assays, API ZYM assays, and antimicrobial susceptibility tests were performed to validate risk-related sequences such as virulence factors, toxin-encoding genes, and antibiotic-resistance genes in the genomes of L. rhamnosus X253 and GG. The results showed that L. rhamnosus GG was able to use L-fucose, had a higher tolerance to bile salt, and adhered better to CaCo-2 cells. In contrast, L. rhamnosus X253 was capable of utilizing D-lactose, withstood larger quantities of hydrogen peroxide, and possessed excellent antioxidant properties. This study confirmed the safety and probiotic properties of L. rhamnosus X253 via complete genome and phenotype analysis, suggesting its potential as a probiotic.
1. Introduction
As dietary supplements or innovative health-promoting products, probiotics are attracting increasing attention for their ability to prevent gastrointestinal disorders and improve health [1,2]. Lactic acid bacteria (LAB), which comprise Lactobacilli and Bifidobacteria, are the predominant components of probiotics. Lactobacillus, an essential component of the intestinal microbiota, has been associated with several potential health benefits [3].
Lacticaseibacillus rhamnosus is a facultatively anaerobic, heterotypic fermenting lactic acid bacterium that is common in traditional fermented foods, animals, humans, and natural habitats [4]. L. rhamnosus has been granted the “Generally Recognized As Safe (GRAS)” status by the US Food and Drug Administration [5] and added to the list of “Qualified Presumption of Safety” (QPS) by the European Food Safety Authority [6]. L. rhamnosus GG, which was isolated from the human intestine, has been shown to be strongly resistant to gastrointestinal digestion [7] and effective both in vitro and in vivo as a nutritional supplement and therapeutic agent [8,9], with anti-inflammatory and antioxidant properties against high-fat diets [10], as well as improving lipid metabolism [11] and alleviating diarrhea [8]. It is worthwhile to investigate how other strains of L. rhamnosus vary from strain GG and whether or not they possess advantageous qualities.
Probiotics exhibit strain-specific properties with regard to their safety and function [12]. It has been hypothesized that improper administration of probiotics may result in four kinds of detrimental effects: systemic infection, creation of toxic metabolites, excessive immunological activation, and transfer of antibiotic resistance and virulence genes [13]. Consequently, it is necessary to confirm the safety and probiotic characteristics of novel isolates prior to evaluating their therapeutic advantages and incorporating them into foods and pharmaceuticals [14]. The analysis of whole genome sequences has proven to be an effective method for assessing the safety and characterization of probiotic strains at the whole-genome level [15].
In this study, we isolated a strain of L. rhamnosus X253 from fermented milk in Xinjiang, China. To further characterize L. rhamnosus X253, its whole genome was sequenced, and a comparative genomic analysis was performed on strain X253 and other L. rhamnosus strains from different sources. Then, using one of the most common commercial strains (L. rhamnosus GG) as a comparison strain, we assessed the safety and efficacy of strain X253 by genomic analysis and phenotypic tests. This study established L. rhamnosus X253 as a safe probiotic candidate with strong antioxidant properties, providing essential information for its future applications.
2. Materials and Methods
2.1. Bacterial Strains and Culture Conditions
L. rhamnosus X253, which was isolated from fermented milk in Xinjiang, China, was provided by Junlebao Dairy Group (Shijiazhuang, China). L. rhamnosus GG was purchased from Chr. Hansen A/S (Hørsholm, Denmark). L. rhamnosus X253 and L. rhamnosus GG were grown in de Man, Rogosa, and Sharpe Broth (MRS; HopeBio, Qingdao, China) at 37 °C under static conditions. The pathogenic bacterium Staphylococcus aureus ATCC 6538 was cultured in Nutrient Broth (HopeBio, Qingdao, China) at 37 °C without shaking.
2.2. Extraction of Nucleic Acids and Genome Sequencing
The Bacterial Genomic DNA Extraction Kit (Tiangen Biotech, Beijing, China) was used to extract genomic DNA, following the manufacturer’s instructions. Total DNA was subjected to purity control by a NanoDrop 2000 Spectrophotometer (Thermo Fisher Scientific, Wilmington, MA, USA) and quantified using a Qubit 3.0 Fluorometer (Life Technologies, Carlsbad, CA, USA) [16]. The genome sequencing of L. rhamnosus X253 was carried out by Amplicon Gene (Shanghai, China) on a combination of Illumina HiSeq and PacBio RSII platforms [17], with an average insert size of 350 bp and 10 kb, respectively.
2.3. Genomic Annotation and Analysis
The raw PacBio reads were assembled into a single scaffold using SMRT Link (version 5.0.1, https://www.pacb.com/support/software-downloads/, accessed on 18 April 2021) [18]. The scaffold was revised using Illumina reads by Quiver (http://www.pacbiodevnet.com/quiver, accessed on 20 April 2021) to generate the complete genome without gaps [19]. The whole genome of strain X253 was submitted to the NCBI database, and gene prediction was conducted using the NCBI’s Prokaryotic Genomes Annotation Pipeline (PGAP, http://www.ncbi.nlm.nih.gov/genome/annotation_prok/, accessed on 13 May 2021) and GeneMarkS annotation software (version 6.1, http://topaz.gatech.edu/GeneMark, accessed on 13 May 2021) [20]. The genes encoding rRNA and tRNA were predicted using barrnap (version 0.8, https://github.com/tseemann/barrnap/, accessed on 14 May 2021) and tRNAscan-SE (version 2.0, http://trna.ucsc.edu/software/, accessed on 14 May 2021) [21]. Genome annotation and analysis were conducted using the COG (Clusters of Orthologous Groups) [22] and KEGG databases [23].
2.4. Evolutionary Position of L. rhamnosus X253
To estimate potential variations among the genomes of 10 L. rhamnosus strains (Table 1), the sizes of the pan-genome, core genome, and unique genes were calculated. Based on the genomic sequences of 10 L. rhamnosus strains, pan-genomic analysis was performed using PGAP (version 1.2.1, https://jaist.dl.sourceforge.net/project/pgap/PGAP, accessed on 10 June 2022). BLAST (version 2.3.0, ftp://ftp.ncbi.nlm.nih.gov/blast/executables/blast+/2.3.0/, accessed on 10 June 2022) was used to align the gene and protein sequences. The identification of homologous genes in different strains was carried out using the Markov Cluster Algorithm (MCL), followed by cluster analysis of homologous genes using the Gene Family (GF) method with parameters set to E-value: 1 × 10−5; score: 50; identity: 50%; coverage: 50%; and inflation: 3 [24]. To visualize the relationships among the 10 L. rhamnosus strains, a Venn diagram was drawn with the VennDiagram R package (version 1.7.3, https://cran.r-project.org/web/packages/VennDiagram/index.html, accessed on 13 June 2022).
Table 1.
L. rhamnosus strains used in this study.
To appreciate the niche adaptation of two distinct sources (Table 1), a cluster analysis was performed using Orthomcl (version 2.0.9, http://orthomcl.org/common/downloads/software/v2.0/, accessed on 13 June 2022) [25]. All orthologous genes were extracted and used to generate the phylogenetic tree by IQ-TREE (version 1.6.12, http://www.cibiv.at/software/iqtree, accessed on 13 June 2022) [26], based on single-copy orthologous genes (SOGs) and the maximum-likelihood (ML) algorithm. Then, tree files with associated data matrices were visualized using iTOL (version 6, https://itol.embl.de/, accessed on 15 June 2022) [27].
The average nucleotide identity (ANI) value was calculated using pyani (https://github.com/widedowquinn/pyani, accessed on 13 June 2022). The X253 genome and the GG genome (accession number: NC_013198) were compared using MUMmer (version 3.23, https://sourceforge.net/projects/mummer/files/latest/download, accessed on 25 June 2022) and LASTZ (version 1.03.54, https://www.geneious.com/plugins/lastz-plugin/, accessed on 25 June 2022) to explore the structural variation between the genomes of the two strains [28]. Additionally, the functional capacity of the 10 strains was investigated by matching the genomic sequences to the eggNOG database (version 5.0, http://eggnogdb.embl.de/#/app/home, accessed on 22 June 2022). Distance matrices based on orthogroup abundance profiles were calculated with the R package vegan (version 2.4.4) and visualized with ggplot2 (version 3.3.5) [29].
2.5. Safety Assessment of L. rhamnosus X253
2.5.1. Prediction of Safety-Related Genes in the Genome
Virulence factors and resistance genes were identified based on the core datasets in the VFDB (Virulence Factors of Pathogenic Bacteria, http://www.mgc.ac.cn/VFs/main.htm, accessed on 26 May 2022) and CARD (Comprehensive Antibiotic Resistance Database, https://card.mcmaster.ca/, accessed on 26 May 2022) databases, with coverage > 60% and identity > 75% [13]. Genes involved in the production of toxins were searched in the PGAP annotation results of the X253 and GG genomes.
2.5.2. Hemolytic Assay
L. rhamnosus X253, L. rhamnosus GG, and S. aureus ATCC 6538 were streaked on Columbia Blood Agar Plates (Land Bridge, Beijing, China) containing fresh sheep blood. After incubation at 37 °C for 48 h, their hemolytic activities were assessed by observing the hydrolysis zones around the colonies [30].
2.5.3. Enzymatic Profiles by API ZYM
Using the API ZYM kit (bioMérieux, Marcy-L’Etoile, France), the activity of 19 enzymes was evaluated. The cupules were filled with 65 µL of bacterial suspension (106 CFU/mL) of L. rhamnosus X253 or L. rhamnosus GG. After incubation at 37 °C for 4 h, the ZYM A and ZYM B reagents were successively added to each cupule. Based on the manufacturer’s instructions, the results were considered positive if the color intensity was more than three [31].
2.5.4. Antimicrobial Susceptibility Test
Following the results of the resistance gene analysis, the minimum inhibitory concentrations (MICs) of GE2270A (Adipogen, San Diego, CA, USA) were determined against L. rhamnosus X253 and L. rhamnosus GG. In addition, the MICs of other antibiotics (Sangon Biotech, Shanghai, China)—including ampicillin, chloramphenicol, erythromycin, gentamicin, streptomycin, tetracycline, and vancomycin—were determined for these two strains in accordance with the ISO 10932:2010 standard (https://www.iso.org/standard/46434.html, accessed on 30 May 2022). In 96-well plates, suspensions of the two strains were combined with antibiotics at varying doses and incubated anaerobically at 37 °C for 48 h. The optical density at 625 nm was measured using a microplate reader (Thermo Labsystems, Franklin, MA, USA). The threshold values for resistance to each antibiotic were derived from the European Food Safety Authority (EFSA) [32].
2.6. Assessment of Probiotic Properties of L. rhamnosus X253
2.6.1. Prediction of Probiotic-Related Genes in the Genome
Probiotic-related genes in the genome of L. rhamnosus X253 were detected in relation to acid tolerance, bile salt tolerance, osmotic pressure regulation, anti-oxidation, and adhesion factors.
2.6.2. Carbohydrate Utilization
The fermentation profiles of L. rhamnosus X253 and L. rhamnosus GG were determined using API 50 CHL strips (bioMérieux, Marcy-L’Etoile, France) according to the manufacturer’s instructions. Genes of enzymes involved in carbohydrate metabolism in the genomes of the L. rhamnosus X253 and GG strains were analyzed using the Carbohydrate-Active Enzyme (CAZY) database (version 6, http://www.cazy.org/: accessed on 24 June 2022).
2.6.3. Artificial Gastric and Bile Salt Tolerance Assay
For the simulated gastric test and bile salt tolerance assay, the method reported by Huang and Adams [33] was adopted. To prepare the artificial gastric juice, pepsin (1:10,000, Sigma, St. Louis, MO, USA) was dissolved in 0.5% (w/v) sterilized saline (pH 3.0) to a final concentration of 3 g/L. To evaluate the resistance to artificial intestinal fluid, 0.1 g of trypsin (1:250, Sigma, St. Louis, MO, USA) and 0.3 g of bile salt (Sigma, St. Louis, MO, USA) were dissolved in 100 mL of 0.5% (w/v) sterilized saline (pH 8.0). The artificial gastric and intestinal fluids were both filtered through 0.22 µm membranes.
The overnight cultures of L. rhamnosus X253 and L. rhamnosus GG were centrifuged (10,000 g for 5 min), washed three times with PBS (pH 7.4), resuspended in artificial gastric juice to a concentration of approximately 108 CFU/mL, and then incubated for 3 h. To determine the quantity of the live bacteria, 100 μL aliquots were obtained every hour for gradient dilution, and the dilutions were plated on MRS agar medium. In addition, bacteria were collected (10,000 g, 5 min), resuspended in artificial intestinal juice, and then incubated for 5 h. As previously described, live bacterial counts were quantified. The survival rate of L. rhamnosus X253 or L. rhamnosus GG was calculated according to the following formula:
where N1 is the total viable count of L. rhamnosus X253 or L. rhamnosus GG after treatment with simulated gastric juice or intestinal fluid, and N0 is the total viable count of L. rhamnosus X253 or L. rhamnosus GG before treatment.
2.6.4. Hydrophobicity and Auto-Aggregation
The bacterial adhesion to hydrocarbons (BATH) assay [34], with modifications, was used to determine the surface hydrophobicity of L. rhamnosus X253 or L. rhamnosus GG. The L. rhamnosus X253 or L. rhamnosus GG was cultured overnight and centrifuged at 10,000× g for 5 min to collect the bacterial cells. The cells were washed three times with PBS (pH 7.4) and suspended in PBS (pH 7.4) to a final cell density of OD600 = 0.60 ± 0.05 (Acontrol). Next, 2 mL of the suspension was thoroughly mixed with 2 mL of xylene, and the mixture was left at room temperature for 0.5 h. The aqueous phase was collected, and its absorbance at 600 nm was measured (Asample). The surface hydrophobicity of L. rhamnosus X253 or L. rhamnosus GG was calculated according to the following formula:
where Acontrol is the absorbance at 0 h and Asample is the absorbance after 0.5 h.
Auto-aggregation was determined by Todorov’s method [35], with minor modifications. The cell density was adjusted to OD600 = 0.60 ± 0.05 (Acontrol), as in the hydrophobic assay. To evaluate auto-aggregation, 4 mL of bacterial suspension was incubated at room temperature for 24 h. Then, 1 mL of the upper layer was carefully aspirated, and the OD600 value was measured (Asample). The auto-aggregation force of L. rhamnosus X253 or L. rhamnosus GG was calculated according to the following formula:
where Acontrol is the absorbance at 0 h and Asample is the absorbance after 24 h.
2.6.5. Adhesion Assay to CaCo-2 Cells
The adhesion assays were conducted in vitro using CaCo-2 cells as described by Petrova et al. [29]. CaCo-2 cells were cultured in DMEM (Dulbecco’s modified Eagle medium, Thermo Fisher Scientific, Wilmington, MA, USA) with 10% heat-inactivated fetal bovine serum, 1% nonessential amino acids, and 1% penicillin–streptomycin solution at 37 °C in an incubator with 5% CO2. The cells were seeded in 6-well plates, cultured at a density of 1 × 106 for 24 h, and then washed twice with prewarmed PBS (pH 7.4). Subsequently, 1 mL of 108 CFU/mL bacterial suspension was added to each treated well and incubated for 3 h with CaCo-2 cells, while 1 mL of DMEM medium was added to the control wells. After washing four times with prewarmed PBS (pH 7.4), the cells were treated with 1 mL of 1% Triton X-100 (Sangon Biotech, Shanghai, China) for 10 min. Finally, the number of viable cell-adhering L. rhamnosus was serially diluted for plate counts and incubated at 37 °C for 48 h. The results were expressed as a ratio of the number of adherent bacteria to the average number of CaCo-2 cells in each well [31].
2.6.6. Tolerance to Hydrogen Peroxide
Samples (100 µL) of L. rhamnosus X253 or L. rhamnosus GG bacterial suspensions (108 CFU/mL) were seeded in 10 mL of MRS broth with different H2O2 concentrations (0, 1, 2, 3, 4, and 5 mM) [36], incubated at 37 °C for 24 h, and the absorbance at OD600 was measured every 2 h.
2.6.7. In Vitro Assessment of Antioxidant Activity
Scavenging activity against 2,2-diphenyl-1-picrylhydrazyl free radicals: The 2,2-diphenyl-1-picrylhydrazyl (DPPH) free-radical-scavenging activity of L. rhamnosus X253 or L. rhamnosus GG was assessed according to the method described by Chen et al. [37]. Three-milliliter bacterial suspensions with different densities (104, 106, and 108 CFU/mL) were mixed with one milliliter of ethanolic DPPH solution (0.2 mM). The mixtures were incubated in the dark at room temperature for 30 min. DPPH solution was mixed with sterilized water as a control group and incubated under the same conditions. The absorbance was measured at a wavelength of 517 nm, and the scavenging ability was calculated according to the following formula:
Scavenging activity against hydroxyl radicals: The hydroxyl radical scavenging activity of L. rhamnosus X253 or L. rhamnosus GG was determined by the method of Tang [36], with some modifications. A reaction mixture containing 0.5 mL of ethanolic salicylic acid solution (5 mM), 0.5 mL of FeSO4 (5 mM), and 0.5 mL of H2O2 (3 mM) was prepared. The mixture was combined with 3 mL of bacterial suspension with different densities (104, 106, and 108 CFU/mL) and adjusted to 5 mL with sterile water, before being incubated at 37 °C for 30 min. After centrifugation at 6000 g for 10 min, the absorbance of the supernatant was measured at 510 nm. The control group received an equal volume of sterilized water instead of the bacterial suspension. The hydroxyl radical scavenging activity was calculated according to the following formula:
2.7. Statistical Analysis
Data from triplicate parallel experiments were used to calculate means and standard deviations. Statistical significance between groups was evaluated using Student’s t test.
3. Results and Discussion
3.1. Genome Properties
The whole genome of L. rhamnosus X253 was sequenced, assembled, and submitted to NCBI under the accession number CP073711. The genomic features of strain X253 were compared with those of the other nine typical L. rhamnosus strains from the two sources—dairy and human intestine (Table 2)—including the commercial strains Lc 705, HN001, R0011, and GG. The average genome size of the 10 strains was approximately 3.0 Mb, which matched the results reported by Lebeer et al. [38]. The number of encoded proteins and the GC content of strain X253 were similar to those of the other nine L. rhamnosus strains. Strain X253 encoded 15 rRNA genes, which was comparable to most other strains, except for HN001 and WQ2, which had only 3 and 2 rRNA genes, respectively. Moreover, L. rhamnosus X253 and strains from the human intestine were devoid of plasmids, unlike the other four strains derived from dairy.
Table 2.
Genome features of 10 representative L. rhamnosus genomes.
3.2. Phylogenetic Analyses
The pan-genomes of the 10 L. rhamnosus strains contained 4427 genes, among which 1958 genes were core genes that were shared by the 10 strains (Figure 1A). With 20 unique genes in total, L. rhamnosus X253 had the lowest number of unique genes compared to the other nine strains. These unique genes encode the ABC transporter and ferrous iron transport protein b. The role of these unique genes for strain X253 needs further investigation.
Figure 1.
Comparative genomic analysis of L. rhamnosus X253 with other L. rhamnosus strains: (A) Venn diagram illustrating the number of genes in the core genome and unique genes of the pan-genome of 10 L. rhamnosus strains. (B) Phylogenetic tree constructed on single-copy orthologous genes to reveal the genetic distance of 10 L. rhamnosus strains. (C) Heatmap of ANI analysis of the genomes of 10 L. rhamnosus strains. (D) Genomic comparison between L. rhamnosus X253 and L. rhamnosus GG.
The phylogenetic tree of the 10 L. rhamnosus strains was constructed based on 1936 single-copy orthologous genes (SOGs) to provide insight into their evolutionary connections and niche adaptations. According to the results, strains originating from dairy and the human intestine were neither completely separated nor clustered, which was consistent with the report by Jeong et al. [39]. L. rhamnosus X253 was more closely related to L. rhamnosus LOCK908 than L. rhamnosus GG (Figure 1B).
Average nucleotide identity (ANI) is the conventional criterion for evaluating whether or not two strains belong to the same species, and 95% is often considered to be the species threshold [40]. The ANI values between all 10 strains exceeded 97%. Consistent with the SOG-based phylogeny, whole-genome ANI analysis revealed that L. rhamnosus X253 was more closely related to L. rhamnosus LOCK908 (ANI approximately 100%) and L. rhamnosus Lc 705 (ANI 99.92%) than to L. rhamnosus GG (ANI 97.55%) (Figure 1C). The clustering of strains mirrored the phylogenetic tree and had no significant correlation with their origins of isolation.
Even though all 10 strains shared a general genomic similarity, a comparison of strain X253 and strain GG revealed specific genetic variations between the two that seemed essential for their niche adaptations. As shown in Figure 1D, there were multiple structural variants between the two genomes of X253 and GG. In comparison to the GG genome, the X253 genome contained a region with complex insertions and deletions between 0.3 and 0.6 Mb. This region comprised the spaCBA pilin gene cluster with a mucus-binding LPXTG motif, which might be important for strain GG to colonize in the human intestinal tract [9]. SpaCBA pilin gene clusters were absent in all dairy-derived isolates [9], which might affect their colonizing capability. Additionally, the X253 genome had four deletions longer than 5000 bp, which were primarily composed of genes related to phagosomes, transposases, recombinases, and carbohydrate metabolism (particularly fucose metabolism). In three insertion sequences larger than 5000 bp in the X253 genome, genes related to cellular SOS response to DNA damage were identified, such as S24 family peptidase (KEM50_RS03990) and LexA family transcriptional regulator (KEM50_RS03995) [41].
3.3. Comparative Functional Analysis between the X253 and GG Genomes
The predicted functional capacities of strain X253 and GG were further investigated in relation to the genomes of the eight other L. rhamnosus strains using the results from the COG functional annotation (Figure 2). For several categories—such as coenzyme transport and metabolism (category H); translation, ribosome structure, and biogenic function (category J); and cell motility, intracellular trafficking, secretion, and vesicular transport (category N)—strains X253 and GG were positioned close to one another, suggesting that these categories were functionally conserved between the two strains. On the other hand, for the categories of carbohydrate transport and metabolism (category G); transcription (category K); replication, recombination, and repair (category L); cell wall, membrane, and envelope biogenesis (category M); and defense mechanisms (category V), strains X253 and GG were far apart. These results suggest that X253 and GG might be different in terms of their carbohydrate usage, and they may have evolved to adapt to different niches by adopting distinct transcriptional, repair, and other regulatory mechanisms. Consequently, the results provide a reference for comparing the functional differences between the two strains.
Figure 2.
PCoA of the predicted functional capacity of 10 L. rhamnosus strains based on mapping of all orthogroups to the eggNOG database. Distance matrices based on orthogroup abundance profiles were calculated with the R package vegan (version 2.4.4) and visualized with ggplot2 (version 3.3.5). Each letter represents a different functional category, and L. rhamnosus X253, L. rhamnosus GG, and the other eight strains are denoted by red circles, green triangles, and blue squares, respectively.
3.4. Safety Evaluation of L. rhamnosus X253
3.4.1. Antibiotic Resistance
Antibiotic resistance in bacteria poses a serious public health threat. Bacteria might acquire resistance to antibiotics by horizontal transfer of plasmids, foreign DNA recombination, or mutations at chromosomal locations [14]. Having no plasmid in its genome, L. rhamnosus X253 might have lower risk of transmitting antibiotic resistance. Similar to strain GG, only one GE2270A resistance gene was identified for strain X253 in the CARD database with coverage >60% and identity >75% (Tables S1 and S2). As a thiopeptide isolated from a strain of Planobispora rosea, GE2270A binds to elongation factor thermo unstable (EF-Tu) and blocks the delivery of aminoacyl tRNAs to the ribosome [42]. The antibacterial activity of GE2270A has been demonstrated in vitro against Staphylococcus aureus, Streptococcus pyogenes, Enterococcus faecalis, Clostridium perfringens, and Propionibacterium acnes, with minimum inhibitory concentrations below 1 μg/mL [42,43]. In this study, GE2270A at 0.5 μg/mL significantly hampered the growth of L. rhamnosus X253 and L. rhamnosus GG. Due to the lack of a criterion to determine whether or not a strain is resistant to GE2270A, it was impossible to accurately judge the resistance of these two strains.
As mentioned in the EFSA guidance document, for L. rhamnosus strains intended for human and veterinary use as feed additives, their susceptibility to a certain spectrum of antibiotics needs to be evaluated [32]. The MIC results showed that both L. rhamnosus X253 and GG were sensitive to ampicillin, erythromycin, gentamicin, streptomycin, and tetracycline. However, both strains were resistant to vancomycin. As Korhonen et al. reported, L. rhamnosus lacked vancomycin binding due to the replacement of D-alanine residues with D-lactic acid at the pentapeptide end of the cell wall [44]. In addition, the presence of the ABC antibiotic efflux pump for chloramphenicol in both strains might have resulted in the reduction in the intracellular concentration of chloramphenicol, thereby increasing the resistance of both strains to chloramphenicol (Table 3), and the results were consistent with those of previous studies [9,45].
Table 3.
MIC values observed for L. rhamnosus X253 and GG against several antibiotics.
3.4.2. Virulence Factor Genes and Toxin-Encoding Genes
In the VFBD database, 215 and 212 virulence genes were predicted for L. rhamnosus X253 and GG, respectively, but all of these genes displayed low similarity, with an identity of less than 75% (Tables S3 and S4). As with L. rhamnosus GG, the genome of X253 did not encode toxic factors, including hemolysin BL (Hbl), non-hemolytic enterotoxin (Nhe), and enterotoxin (cytotoxin K). The hemolytic activity of both strains was further confirmed by phenotypic analysis. When cultured on Columbia Blood Agar Plates containing fresh sheep blood for 48 h, neither L. rhamnosus X253 nor GG exhibited hemolytic activity, whereas S. aureus ATCC 6538 demonstrated significant β-hemolytic activity (Figure 3).
Figure 3.
Hemolytic ability of L. rhamnosus GG and X253: As a positive control, S. aureus ATCC 6538 generated a clearly visible zone of β-hemolytic activity.
3.4.3. Enzymatic Profile by API ZYM
L. rhamnosus X253 and GG both contained the gene uidA encoding β-glucuronidase. β-Glucuronidase is a potentially carcinogenic enzyme that increases the risk of gastric cancer and inflammatory bowel disease [46]. Therefore, it was necessary to analyze the extracellular enzyme profiles of both strains phenotypically. The enzyme profile of L. rhamnosus X253 was similar to that of L. rhamnosus GG (Table 4). L. rhamnosus X253 and GG produced several non-hazardous enzymes, including esterase, leucine arylamidase, valine arylamidase, cystine arylamidase, acid phosphatase, and naphthol-AS-BI-phosphohydrolase. No β-glucuronidase activity was found, indicating that both strains are safe.
Table 4.
Enzymatic profiles and assay of toxic metabolic production.
3.5. Assessment of Probiotic Properties
3.5.1. Carbohydrate Fermentation Profiles
As the genes involved in carbohydrate transport and metabolism were considerably different between L. rhamnosus X253 and L. rhamnosus GG, phenotypic analysis was conducted to determine the differences between the two strains with regard to carbohydrate utilization. The carbohydrate usage profiles revealed that L. rhamnosus X253 and GG were able to use 23 and 19 carbohydrates, respectively. Utilization of carbohydrates is dependent on functional transporters and intact metabolic pathways. Discrepancies between the two strains may result from the gain and loss of metabolism-related genes in their evolution in distinct niches. Strain GG was capable of using D-arabinose, dulcitol, and L-fucose, whereas strain X253 did not possess these abilities but could ferment L-sorbose, L-rhamnose, methyl-α-D-glucopyranoside, D-maltose, D-lactose, D-saccharose, and D-turanose (Table 5).
Table 5.
Carbohydrate fermentation profile assessed by API 50 CHL test strips.
Genetic differences between the two strains may explain some of their differences. The genome of L. rhamnosus GG contains a tagatose-6-phosphate pathway (lacABCD) and a lactose PTS (lacFEG); however, the antiterminator (lacT) and the phospho-β-galactosidase (lacG) genes are mutated and inactive, making GG incapable of metabolizing D-lactose [7]. In strain X253, the lacT and lacG genes were conserved, consistent with the fact that lactose is an important carbohydrate in dairy products. In contrast, L. rhamnosus GG utilized L-fucose better than L. rhamnosus X253. Moreover, consistent with the fact that strain X253 cannot use L-fucose, it did not encode the fcsR fucose operon repressor, fucU, or fucI isomerase [47]. As an important carbon source in the intestine, L-fucose can be found in a variety of fucosylated compounds, including human mucins and glycoproteins [47].
3.5.2. Artificial Gastric Fluid and Intestinal Fluid Tolerance Assays
L. rhamnosus GG is a typical strain with a high tolerance to the conditions in the gastrointestinal tract [8]. The survivability of L. rhamnosus X253 and L. rhamnosus GG in artificial gastric fluids (AGF) and artificial intestinal fluids (AIF) is shown in Figure 4. The survival rates of both L. rhamnosus X253 and GG remained above 90% when incubated in AGF (pH 3.0) for 3 h. Genes encoding proteins that are involved in acid tolerance—such as dTDP-glucose 4,6-dehydratase [48], 4-hydroxy-tetrahydrodipicolinate synthase, ATP-dependent intracellular protein ClpP [49], and F0F1-ATPases (such as atpC, atpD, atpG, atpA, atpH, atpF, and atpB) [50]—were found in the genomes of both strains. These genes might contribute to the adaptation of L. rhamnosus X253 and GG in low-pH environments.
Figure 4.
Artificial gastric fluid and intestinal fluid tolerance of L. rhamnosus X253 and GG: Survival rate of L. rhamnosus X253 and GG (108 CFU/mL) in artificial gastric fluids at pH 3.0, followed by artificial intestinal fluids at pH 8.0.
Despite this, the survival rate of GG was maintained around 80% after a further 5 h of AIF (pH 8.0) stress, whereas the survival rate of X253 declined dramatically to approximately 55%. This difference might be related to the fact that L. rhamnosus GG possesses genes encoding taurine transport systems (tauABC), but L. rhamnosus X253 does not. These genes may be involved in the binding of bile salts [51], allowing GG to tolerate bile salts better than X253.
3.5.3. Adhesion Ability
The hydrophobicity and auto-aggregation of bacteria are indicators of the non-specific adhesion of probiotics to the intestine [52]. The hydrophobicity and auto-aggregation capacity of L. rhamnosus X253 were 51.43 ± 3.49% and 76.08 ± 3.23%, respectively, and these properties were significantly lower than those of GG (Figure 5). Using CaCo-2 cells, the adhesion of L. rhamnosus X253 and GG was further evaluated. The results showed that each CaCo-2 cell was attached by an average of 9.57 ± 0.87 GG cells, which was significantly higher than that of strain X253. The spaCBA pilin gene cluster is not commonly found in dairy-derived strains of L. rhamnosus [9], which perhaps explains why strain X253 had a lower adhesion capability than strain GG. Moreover, the adhesion embodied in strain X253 may be linked to other genes, such as the molecular chaperones dnaK and groEL [53].
Figure 5.
Comparative analysis of L. rhamnosus X253 and L. rhamnosus GG for hydrophobicity, auto-aggregation and adhesion to CaCo-2 cells; *: p < 0.05, **: p < 0.01. (A) Hydrophobicity and auto-aggregation. (B) Adhesion to CaCo-2 cells.
3.5.4. Hydrogen Peroxide Tolerance Assay
By adding different concentrations of H2O2 to MRS broth, the tolerance of L. rhamnosus X253 and GG to H2O2 was determined. The results demonstrated that the lag period of both strains increased with increasing H2O2 concentrations, possibly owing to the oxidative damage caused to the bacteria by the high H2O2 concentration. In addition, L. rhamnosus X253 was able to survive at a concentration of 3 mM H2O2—higher than GG could handle (Figure 6A,B), and also much higher than other L. rhamnosus strains, as previously reported [29].
Figure 6.
Comparative analysis of hydrogen peroxide tolerance and antioxidant capacity of L. rhamnosus X253 and L. rhamnosus GG: (A,B) Growth of L. rhamnosus X253 (A) and L. rhamnosus GG (B) in MRS broth containing different concentrations of hydrogen peroxide. (C,D) Scavenging rates of DPPH (C) and hydroxyl radicals (D) by bacterial suspensions with different densities (104, 106, and 108 CFU/mL) of strains X253 and GG. *: p < 0.05, **: p < 0.01.
3.5.5. Antioxidant Activity In Vitro
Certain metabolites generated by probiotics have been demonstrated to decrease oxidative damage, making them helpful in delaying aging and preventing chronic illness [54]. Studies have confirmed that L. rhamnosus GG can ameliorate alcohol-induced oxidative damage in the murine intestine and boost antioxidant indicators in the human body [55,56]. The rates of scavenging of DPPH and hydroxyl radicals by bacterial suspensions of strains X253 and GG revealed that the antioxidant capacity of both strains was proportional to the bacterial densities. Strains X253 and GG both had good antioxidant capacity, which might have been due to the presence of antioxidant stress genes in their genomes, such as thioredoxin, glutathione peroxidase, pyruvate oxidase, and NADH-dependent flavin oxidoreductase. Notably, strain X253 demonstrated higher levels of DPPH scavenging ability than strain GG. In addition, strain X253 was substantially more effective than GG at 108 CFU/mL in scavenging hydroxyl free radicals, with rates of 30.21 ± 1.75% and 26.08 ± 1.21%, respectively. According to these results, strain X253 had greater antioxidant activity than strain GG, suggesting its potential as a disease-preventive and anti-aging agent [57,58].
4. Conclusions
A comparative genomic analysis of 10 L. rhamnosus strains revealed that the dairy-derived strain X253 was most closely linked to the human-intestine-derived strain LOCK908, and the clustering pattern did not correspond well to the strains’ origin of isolation. The genetic differences between strain X253 and strain GG enable them to occupy different niches. Using genetic analysis and phenotypic validation, strain X253 was confirmed to be comparable to strain GG in terms of safety. The difference in probiotic characteristics between strain X253 and strain GG could also be attributed to their origins of isolation. Notably, strain X253 demonstrated superior hydrogen peroxide tolerance and antioxidant activity compared to strain GG. In summary, this study on the phenotypic and genetic aspects of L. rhamnosus X253 confirmed its safety and probiotic properties, making it a promising probiotic candidate.
Supplementary Materials
The following supporting information can be downloaded at: https://www.mdpi.com/article/10.3390/microorganisms11010140/s1, Table S1: Antibiotic-resistance genes detected in L. rhamnosus X253; Table S2: Antibiotic-resistance genes detected in L. rhamnosus GG; Table S3: Virulence-related genes detected in L. rhamnosus X253; Table S4: Virulence-related genes detected in L. rhamnosus GG.
Author Contributions
Conceptualization, D.Z.; methodology, Y.L. and J.Z.; software, L.Z.; validation, L.Z. and Y.Z.; formal analysis, L.Z.; investigation, L.Z.; resources, D.Z.; data curation, L.Z.; writing—original draft preparation, L.Z.; writing—review and editing, J.Z.; visualization, L.Z.; supervision, Y.L.; project administration, L.Z. and Y.L.; funding acquisition, L.Z. and Y.L. All authors have read and agreed to the published version of the manuscript.
Funding
This work was supported by the Science and Technology Project of the Shanghai Institute of Quality Inspection and Technical Research (grant number KY-2021-1-SP) and the Science and Technology Project of the Shanghai Municipal Market Supervision Administration (grant number 2022-49).
Institutional Review Board Statement
Not applicable.
Informed Consent Statement
Not applicable.
Data Availability Statement
The full genome data of L. rhamnosus X253 can be found in NCBI GenBank under the accession number CP073711.
Acknowledgments
We thank Shanghai Amplicongene Co., Ltd. for help in high-throughput data analysis.
Conflicts of Interest
Junlebao Dairy Group isolated and provided L. rhamnosus X253. All authors declare no competing financial interest or personal relationships that could have appeared to influence the work in this manuscript.
References
- Huang, Y.Y.; Liu, D.M.; Jia, X.Z.; Liang, M.H.; Lu, Y.; Liu, J. Whole genome sequencing of Lactobacillus plantarum DMDL 9010 and its effect on growth phenotype under nitrite stress. LWT-Food Sci. Technol. 2021, 149, 111778. [Google Scholar] [CrossRef]
- Wu, Y.P.; Liu, D.M.; Zhao, S.; Huang, Y.Y.; Yu, J.J.; Zhou, Q.Y. Assessing the safety and probiotic characteristics of Bacillus coagulans 13002 based on complete genome and phenotype analysis. LWT-Food Sci. Technol. 2022, 155, 112847. [Google Scholar] [CrossRef]
- Damodharan, K.; Palaniyandi, S.A.; Yang, S.H.; Suh, J.W. Functional probiotic characterization and in vivo cholesterol-lowering activity of Lactobacillus helveticus isolated from fermented cow milk. J. Microbiol. Biotechnol. 2016, 26, 1675–1686. [Google Scholar] [CrossRef] [PubMed]
- Peirotén, Á.; Landete, J.M. Natural and engineered promoters for gene expression in Lactobacillus species. Appl. Microbiol. Biotechnol. 2020, 104, 3797–3805. [Google Scholar] [CrossRef] [PubMed]
- Stavropoulou, E.; Bezirtzoglou, E. Probiotics in medicine: A long debate. Front. Immunol. 2020, 11, 2192. [Google Scholar] [CrossRef] [PubMed]
- EFSA Panel on Biological Hazards (BIOHAZ); Koutsoumanis, K.; Allende, A.; Alvarez-Ordóñez, A.; Bolton, D.; Bover-Cid, S.; Chemaly, M.; Davies, R.; De Cesare, A.; Hilbert, F.; et al. Update of the list of QPS-recommended biological agents intentionally added to food or feed as notified to EFSA 15: Suitability of taxonomic units notified to EFSA until September 2021. EFSA J. 2022, 20, e07045. [Google Scholar] [CrossRef] [PubMed]
- Huang, D.; Yang, B.; Chen, Y.; Stanton, C.; Ross, R.P.; Zhao, J.; Zhang, H.; Chen, W. Comparative genomic analyses of Lactobacillus rhamnosus isolated from Chinese subjects. Food Biosci. 2020, 36, 100659. [Google Scholar] [CrossRef]
- Shehata, H.R.; Newmaster, S.G. A validated real-time PCR method for the specific identification of probiotic strain Lactobacillus rhamnosus GG (ATCC 53103). J. AOAC Int. 2020, 103, 1604–1609. [Google Scholar] [CrossRef]
- Segers, M.E.; Lebeer, S. Towards a better understanding of Lactobacillus rhamnosus GG—Host interactions. Microb. Cell Fact. 2014, 13, S7. [Google Scholar] [CrossRef]
- Kankainen, M.; Paulin, L.; Tynkkynen, S.; von Ossowski, I.; Reunanen, J.; Partanen, P.; Satokari, R.; Vesterlund, S.; Hendrickx, A.P.; Lebeer, S.; et al. Comparative genomic analysis of Lactobacillus rhamnosus GG reveals pili containing a human-mucus binding protein. Proc. Natl. Acad. Sci. USA 2009, 106, 17193–17198. [Google Scholar] [CrossRef]
- Yau, Y.F.; El-Nezami, H.; Galano, J.M.; Kundi, Z.M.; Durand, T.; Lee, J.C.Y. Lactobacillus rhamnosus GG and oat beta-glucan regulated fatty acid profiles along the gut-liver-brain axis of mice fed with high fat diet and demonstrated antioxidant and anti-inflammatory potentials. Mol. Nutr. Food Res. 2020, 64, 2000566. [Google Scholar] [CrossRef] [PubMed]
- Zhang, C.; Yu, X.; Wang, D.; Gui, Y.; Wang, C.; Li, Q.; Wang, J.; Yin, B.; Pan, Z.; Gu, R. Rapid strain-specific identification of two Lactobacillus rhamnosus strains using PCR based on gene family analysis. LWT-Food Sci. Technol. 2021, 146, 111395. [Google Scholar] [CrossRef]
- Fu, X.; Lyu, L.; Wang, Y.; Zhang, Y.; Guo, X.; Chen, Q.; Liu, C. Safety assessment and probiotic characteristics of Enterococcus lactis JDM1. Microb. Pathog. 2022, 163, 105380. [Google Scholar] [CrossRef] [PubMed]
- Saroj, D.B.; Gupta, A.K. Genome based safety assessment for Bacillus coagulans strain LBSC (DSM 17654) for probiotic appli-cation. Int. J. Food Microbiol. 2020, 318, 108523. [Google Scholar] [CrossRef]
- Hussein, W.E.; Abdelhamid, A.G.; Rocha-Mendoza, D.; García-Cano, I.; Yousef, A.E. Assessment of safety and probiotic traits of Enterococcus durans OSY-EGY, isolated from Egyptian artisanal cheese, using comparative genomics and phenotypic analyses. Front. Microbiol. 2020, 11, 608314. [Google Scholar] [CrossRef] [PubMed]
- Emam, A.; Wu, X.; Xu, S.; Wang, L.; Liu, S.; Wang, B. Stalled replication fork protection limits cGAS–STING and P-body-dependent innate immune signalling. Nat. Cell Biol. 2022, 24, 1154–1164. [Google Scholar] [CrossRef] [PubMed]
- Xiang, Y.; Wang, Y.; Shen, H.; Wang, D. The draft genome sequence of Pseudomonas putida strain TGRB4, an aerobic bacterium capable of producing methylmercury. Curr. Microbiol. 2020, 77, 522–527. [Google Scholar] [CrossRef]
- Ardui, S.; Ameur, A.; Vermeesch, J.; Hestand, M. Single molecule real-time (SMRT) sequencing comes of age: Applications and utilities for medical diagnostics. Nucleic Acids Res. 2018, 46, 2159–2168. [Google Scholar] [CrossRef]
- Myers, E.W.; Sutton, G.G.; Delcher, A.L.; Dew, I.M.; Fasulo, D.P.; Flanigan, M.J.; Kravitz, S.A.; Mobarry, C.M.; Reinert, K.H.; Remington, K.A.; et al. A whole-genome assembly of Drosophila. Science 2000, 287, 2196–2204. [Google Scholar] [CrossRef]
- Besemer, J.; Lomsadze, A.; Borodovsky, M. GeneMarkS: A self-training method for prediction of gene starts in microbial genomes. Nucleic Acids Res. 2001, 29, 2607–2618. [Google Scholar] [CrossRef]
- Jin, Q.; Jiang, Q.; Zhao, L.; Su, C.; Li, S.; Si, F.; Li, S.; Zhou, C.; Mu, Y.; Xiao, M. Complete genome sequence of Bacillus velezensis S3-1, a potential biological pesticide with plant pathogen inhibiting and plant promoting capabilities. J. Biotechnol. 2017, 259, 199–203. [Google Scholar] [CrossRef] [PubMed]
- Juhl, J.L.; Philippe, J.; Michael, K.; Christian, V.M.; Jean, M.; Tobias, D.; Peer, B. eggNOG: Automated construction and anno-tation of orthologous groups of genes. Nucleic Acids Res. 2008, 36, D250–D254. [Google Scholar]
- Ogata, H.; Goto, S.; Sato, K.; Fujibuchi, W.; Bono, H.; Kanehisa, M. KEGG: Kyoto encyclopedia of genes and genomes. Nucleic Acids Res. 1999, 27, 29–34. [Google Scholar] [CrossRef] [PubMed]
- Harris, H.M.B.; Bourin, M.J.B.; Claesson, M.J.; O’Toole, P.W. Phylogenomics and comparative genomics of Lactobacillus sali-varius, a mammalian gut commensal. Microb. Genom. 2017, 3, e000115. [Google Scholar] [PubMed]
- Kelleher, P.; Bottacini, F.; Mahony, J.; Kilcawley, K.N.; van Sinderen, D. Comparative and functional genomics of the Lacto-coccus lactis taxon; insights into evolution and niche adaptation. BMC Genom. 2017, 18, 267. [Google Scholar] [CrossRef] [PubMed]
- Nguyen, L.T.; Schmidt, H.A.; von Haeseler, A.; Minh, B.Q. IQ-TREE: A fast and effective stochastic algorithm for estimating maximum-likelihood phylogenies. Mol. Biol. Evol. 2015, 32, 268–274. [Google Scholar] [CrossRef]
- Letunic, I.; Bork, P. Interactive tree of life (iTOL) v3: An online tool for the display and annotation of phylogenetic and other trees. Nucleic Acids Res. 2016, 44, W242–W245. [Google Scholar] [CrossRef]
- Guo, Y.; Li, Y.; Su, L.; Chang, D.; Liu, W.; Wang, T.; Yuan, Y.; Fang, X.; Wang, J.; Li, T.; et al. Comparative genomic analysis of Klebsiella pneumonia (LCT-KP214) and a mutant strain (LCT-KP289) obtained after spaceflight. BMC Genom. 2014, 15, 589. [Google Scholar] [CrossRef]
- Petrova, M.I.; Macklaim, J.M.; Wuyts, S.; Verhoeven, T.; Vanderleyden, J.; Gloor, G.B.; Lebeer, S.; Reid, G. Comparative genomic and phenotypic analysis of the vaginal probiotic Lactobacillus rhamnosus GR-1. Front. Microbiol. 2018, 9, 1278. [Google Scholar] [CrossRef]
- Jeon, H.L.; Lee, N.K.; Yang, S.J.; Kim, W.S.; Paik, H.D. Probiotic characterization of Bacillus subtilis P223 isolated from kimchi. Food Sci. Biotechnol. 2017, 26, 1641–1648. [Google Scholar] [CrossRef]
- Jang, Y.J.; Gwon, H.M.; Jeong, W.S.; Yeo, S.H.; Kim, S.Y. Safety evaluation of Weissella cibaria JW15 by phenotypic and genotypic property analysis. Microorganisms 2021, 9, 2450. [Google Scholar] [CrossRef] [PubMed]
- EFSA Panel on Additives and Products or Substances Used in Animal Feed (FEEDAP). Guidance on the assessment of bacterial susceptibility to anti-microbials of human and veterinary importance. EFSA J. 2012, 10, 2740. [Google Scholar]
- Huang, Y.; Adams, M.C. In vitro assessment of the upper gastrointestinal tolerance of potential probiotic dairy propioni-bacteria. Int. J. Food Microbiol. 2004, 91, 253–260. [Google Scholar] [CrossRef] [PubMed]
- Sadishkumar, V.; Jeevaratnam, K. In vitro probiotic evaluation of potential antioxidant lactic acid bacteria isolated from idli batter fermented with Piper betle leaves. Int. J. Food Sci. Technol. 2017, 52, 329–340. [Google Scholar] [CrossRef]
- Todorov, S.D.; Holzapfel, W.; Nero, L.A. In vitro evaluation of beneficial properties of bacteriocinogenic Lactobacillus plantarum ST8Sh. Probiotics Antimicrob. Proteins 2017, 9, 194–203. [Google Scholar] [CrossRef]
- Tang, W.; Xing, Z.; Li, C.; Wang, J.; Wang, Y. Molecular mechanisms and in vitro antioxidant effects of Lactobacillus plantarum MA2. Food Chem. 2017, 221, 1642–1649. [Google Scholar] [CrossRef]
- Chen, P.; Zhang, Q.; Dang, H.; Liu, X.; Tian, F.; Zhao, J.; Chen, Y.; Zhang, H.; Chen, W. Screening for potential new probiotic based on probiotic properties and α-glucosidase inhibitory activity. Food Control 2014, 35, 65–72. [Google Scholar] [CrossRef]
- Lebeer, S.; Vanderleyden, J.; De Keersmaecker, S.C.J. Genes and molecules of lactobacilli supporting probiotic action. Microbiol. Mol. Biol. Rev. 2008, 72, 728–764. [Google Scholar] [CrossRef]
- Jeong, H.; Choi, S.; Park, G.S.; Ji, Y.; Park, S.; Holzapfel, W.; Mathara, J.; Kang, J. Comparative genomic analysis of Lactobacillus rhamnosus BFE5264, a probiotic strain isolated from traditional maasai fermented milk. Microbiol. Biotechnol. Lett. 2019, 47, 25–33. [Google Scholar] [CrossRef]
- Sun, Z.; Zhang, W.; Guo, C.; Yang, X.; Liu, W.; Wu, Y.; Song, Y.; Kwok, L.Y.; Cui, Y.; Menghe, B.; et al. Comparative genomic analysis of 45 type strains of the genus Bifidobacterium: A snapshot of its genetic diversity and evolution. PLoS ONE 2015, 10, e0117912. [Google Scholar] [CrossRef]
- Takashima, K.; Nagao, S.; Kizawa, A.; Suzuki, T.; Dohmae, N.; Hihara, Y. The role of transcriptional repressor activity of LexA in salt-stress responses of the cyanobacterium Synechocystis sp. PCC 6803. Sci. Rep. 2020, 10, 17393. [Google Scholar] [CrossRef] [PubMed]
- Wahyudi, H.; McAlpine, S.R. Predicting the unpredictable: Recent structure–activity studies on peptide-based macrocycles. Bioorg. Chem. 2015, 60, 74–97. [Google Scholar] [CrossRef] [PubMed]
- Selva, E.; Beretta, G.; Montanini, N.; Saddler, G.S.; Gastaldo, L.; Ferrari, P.; Lorenzetti, R.; Landini, P.; Ripamonti, F.; Goldstein, B.P.; et al. Antibiotic GE2270 a: A novel inhibitor of bacterial protein synthesis. I. Isolation and characterization. J. Antibiot. 1991, 44, 693–701. [Google Scholar] [CrossRef] [PubMed]
- Korhonen, J.M.; Van Hoek, A.H.; Saarela, M.; Huys, G.; Tosi, L.; Mayrhofer, S.; Wright, A.V. Antimicrobial susceptibility of Lactobacillus rhamnosus. Benefic. Microbes 2010, 1, 75–80. [Google Scholar] [CrossRef] [PubMed]
- Schwarz, S.; Kehrenberg, C.; Doublet, B.; Cloeckaert, A. Molecular basis of bacterial resistance to chloramphenicol and florfenicol. FEMS Microbiol. Rev. 2004, 28, 519–542. [Google Scholar] [CrossRef]
- Heavey, P.M.; Rowland, I.R. Microbial-gut interactions in health and disease. Gastrointestinal cancer. Best Pract. Res. Clin. Gastroenterol. 2004, 18, 323–336. [Google Scholar] [CrossRef]
- Becerra, J.E.; Yebra, M.J.; Monedero, V. An L-fucose operon in the probiotic Lactobacillus rhamnosus GG is involved in adaptation to gastrointestinal conditions. Appl. Environ. Microbiol. 2015, 81, 3880–3888. [Google Scholar] [CrossRef]
- Hamon, E.; Horvatovich, P.; Marchioni, E.; Aoudé-Werner, D.; Ennahar, S. Investigation of potential markers of acid resistance in Lactobacillus plantarum by comparative proteomics. J. Appl. Microbiol. 2013, 116, 134–144. [Google Scholar] [CrossRef]
- Jia, F.F.; Zhang, L.J.; Pang, X.H.; Gu, X.X.; Abdelazez, A.; Liang, Y.; Sun, S.R.; Meng, X.C. Complete genome sequence of bac-teriocin-producing Lactobacillus plantarum KLDS1.0391, a probiotic strain with gastrointestinal tract resistance and adhesion to the intestinal epithelial cells. Genomics 2017, 109, 432–437. [Google Scholar] [CrossRef]
- Futai, M.; Kanazawa, H. Structure and function of proton-translocating adenosine triphosphatase (F0F1). Microbiol. Rev. 1983, 47, 285–312. [Google Scholar] [CrossRef]
- El Aila, N.A.; Tency, I.; Claeys, G.; Verstraelen, H.; Saerens, B.; Santiago, G.L.; De Backer, E.; Cools, P.; Temmerman, M.; Verhelst, R.; et al. Identification and genotyping of bacteria from paired vaginal and rectal samples from pregnant women indicates similarity between vaginal and rectal microflora. BMC Infect. Dis. 2009, 9, 167. [Google Scholar] [CrossRef]
- Riaz, M.S.; Mehwish, M.; Siddiq, M.; Haobin, Z.; Zhu, J.; Yan, L.; Shao, D.; Xu, X.; Shi, J. Identification, characterization, and probiotic potential of Lactobacillus rhamnosus isolated from human milk. LWT-Food Sci. Technol. 2017, 84, 271–280. [Google Scholar] [CrossRef]
- Ye, K.; Li, P.; Gu, Q. Complete genome sequence analysis of a strain Lactobacillus pentosus ZFM94 and its probiotic character-istics. Genomics 2020, 112, 3142–3149. [Google Scholar] [CrossRef] [PubMed]
- Pastoriza, S.; Delgado-Andrade, C.; Haro, A.; Rufián-Henares, J.A. A physiologic approach to test the global antioxidant response of foods. The GAR method. Food Chem. 2011, 129, 1926–1932. [Google Scholar] [CrossRef]
- Forsyth, C.B.; Farhadi, A.; Jakate, S.M.; Tang, Y.; Shaikh, M.; Keshavarzian, A. Lactobacillus GG treatment ameliorates alcohol-induced intestinal oxidative stress, gut leakiness, and liver injury in a rat model of alcoholic steatohepatitis. Alcohol 2009, 43, 163–172. [Google Scholar] [CrossRef] [PubMed]
- Martarelli, D.; Verdenelli, M.C.; Scuri, S.; Cocchioni, M.; Silvi, S.; Cecchini, C.; Pompei, P. Effect of a probiotic intake on oxidant and antioxidant parameters in plasma of athletes during intense exercise training. Curr. Microbiol. 2011, 62, 1689–1696. [Google Scholar] [CrossRef]
- Garigan, D.; Hsu, A.L.; Fraser, A.G.; Kamath, R.S.; Ahringer, J.; Kenyon, C. Genetic analysis of tissue aging in Caenorhabditis elegans: A role for heat-shock factor and bacterial proliferation. Genetics 2002, 161, 1101–1112. [Google Scholar] [CrossRef]
- Kaushik, J.K.; Kumar, A.; Duary, R.K.; Mohanty, A.K.; Grover, S.; Batish, V.K. Functional and probiotic attributes of an in-digenous isolate of Lactobacillus plantarum. PLoS ONE 2009, 4, e8099. [Google Scholar] [CrossRef]
Disclaimer/Publisher’s Note: The statements, opinions and data contained in all publications are solely those of the individual author(s) and contributor(s) and not of MDPI and/or the editor(s). MDPI and/or the editor(s) disclaim responsibility for any injury to people or property resulting from any ideas, methods, instructions or products referred to in the content. |
© 2023 by the authors. Licensee MDPI, Basel, Switzerland. This article is an open access article distributed under the terms and conditions of the Creative Commons Attribution (CC BY) license (https://creativecommons.org/licenses/by/4.0/).